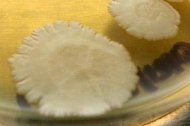

Ученые из Калифорнийского университета в Дейвисе обнаружили бактерию, которая размножается в космосе на 60% активнее, чем на Земле.
Ученые из Калифорнийского университета в Дейвисе обнаружили бактерию, которая размножается в космосе на 60% активнее, чем на Земле. Некоторые виды бактерий чувствуют себя в космосе как дома, при этом, как выяснилось в ходе нового исследования, один из видов бактерий, Bacillus safensis, развивается в условиях микрогравитации на Международной космической станции интенсивнее, чем на Земле, сообщает Хроника.инфо со ссылкой на AstroNews.ru.
Это исследование проводилось в рамках проекта MECCURI, в реализации которого принимали участие добровольцы-любители и микробиологи-профессионалы. Участники проекта собрали образцы бактерий на Земле и отправили их на МКС, чтобы посмотреть, как эти микроорганизмы будут развиваться в условиях микрогравитации.
Удивительная способность бактерий выживать в космосе уже была показана ранее в экспериментах, поставленных в открытом космосе снаружи МКС, однако в рамках проекта MECCURI изучалась именно способность бактерий выживать в условиях, поддерживающихся внутри космической станции.
«Теплые, влажные, богатые кислородом условия на борту МКС разительно отличаются от вакуума космического пространства, – сказал доктор Дэвид Койл из Калифорнийского университета в Дейвисе, США, микробиолог и главный автор этого нового исследования.
Интересно отметить, что подавляющее большинство из этих 48 штаммов бактерий, отправленных на МКС, развивались на борту космической станции примерно с такой же скорстью, что и на Земле.
Однако штамм Bacillus safensis показал на космической станции скорость роста, на 60 процентов превышающую скорость роста этого вида бактерий на поверхности Земли. Бактерии этого вида оказались в космосе не впервые: они были обнаружены на борту марсианского ровера Opportunity, а также на борту его «брата-близнеца», ровера Spirit, в 2004 г.
По словам авторов работы, изучение поведения бактерий в условиях микрогравитации поможет при планировании долгосрочных пилотируемых космических миссий.
По материалам hronika.info
checheninfo.ru
Ученые из Калифорнийского университета в Дейвисе обнаружили бактерию, которая размножается в космосе на 60% активнее, чем на Земле.
Ученые из Калифорнийского университета в Дейвисе обнаружили бактерию, которая размножается в космосе на 60% активнее, чем на Земле. 